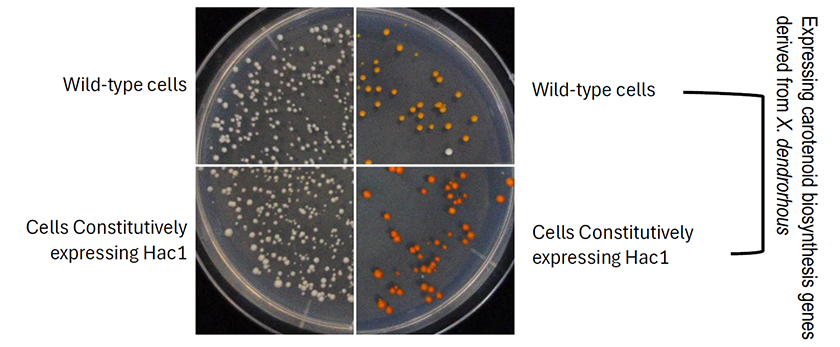

2026.04.01
Production of heterologous secretory proteins and lipid molecules from yeast cells constitutively provoking the ER stress response
Organelle Control ・ Assistant Professor ・ Yuki Ishiwata-Kimata
The production of heterologous secretory proteins and lipid molecules from yeasts is a promising biotechnology. The endoplasmic reticulum (ER) is an organelle in which these materials are synthesized. Genetic modifications that upregulate ER function may lead to higher production of these materials. In many yeast species, including Saccharomyces cerevisiae, the ER stress response is governed by the transcription factor Hac1, which transcriptionally induces various ER-related genes in response to ER dysfunction. While S. cerevisiae mutants constitutively overexpressing Hac1 contained the ER that was artificially enlarged and enforced, they grew fairly slowly and did not seem to be suitable for industrial use. In our current research, we solved this drawback of the constitutively Hac1-expressing cells through deletion of a histone-demodification enzyme, expanding possibilities for their application in the production of commercially beneficial materials.
Yuki Ishiwata-Kimata NAIST Edge BIO, e0035. (2026).